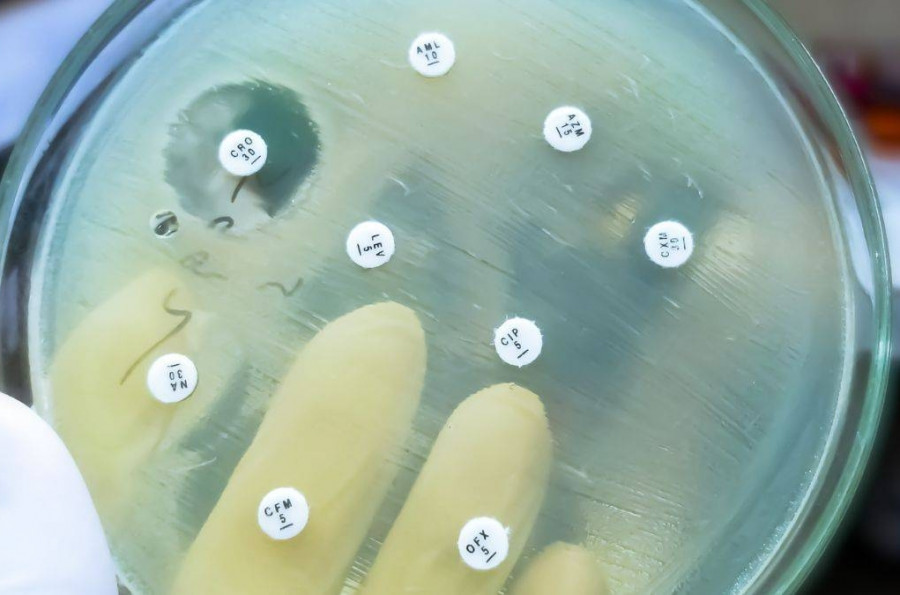

.
Brecha en la armadura bacteriana: El avance que permite a los antibióticos volver a ser letales
NUEVA YORK,EE.UU./ SALUD DIGITAL.- La resistencia a los antimicrobianos es una grave crisis sanitaria mundial, con las bacterias gramnegativas resistentes a los fármacos representando un desafío particular. Se trata de microbios que están envueltos en una formidable membrana externa que actúa como escudo, impidiendo que muchos antibióticos alcancen sus objetivos dentro de la célula.
Esta armadura es una de las principales razones por las que desarrollar nuevos fármacos contra ellos es tan difícil y por las que los existentes están perdiendo rápidamente su eficacia. Por todo ello, los médicos cuentan con pocas opciones de tratamiento.
Ahora, en la lucha global contra la resistencia a los antimicrobianos, un equipo internacional de investigación ha revelado un nuevo y poderoso avance. Partiendo de las distintivas nanopartículas Janus de “dos caras”, el equipo logró demostrar una estrategia que funciona en conjunto con los antibióticos para superar las defensas de las bacterias gramnegativas altamente resistentes. Dichas partículas rompen la membrana protectora externa de las bacterias, creando una vía de entrada para medicamentos que antes eran ineficaces.
El profesor asociado Martijn Zwama y el profesor Kunihiko Nishino dirigieron la investigación en el Instituto de Investigación Científica e Industrial (SANKEN) de la Universidad de Osaka, en colaboración con el profesor Yan Yu (Universidad de Indiana, EE. UU.), quien dirigió el diseño e ingeniería de las nanopartículas anfifílicas Janus (JNP). Estas partículas, nombradas en honor al dios romano de dos caras, tienen una naturaleza dual: un lado es hidrófilo o atraído por el agua, y el otro es hidrófobo o repelido por el agua. Gracias a esta estructura, las JNP interactúan con la membrana externa bacteriana y la desestabilizan.
“Estas nanopartículas actúan como un aliado perfecto para los antibióticos”
Aunque las JNP en sí mismas no son letales para las bacterias, crean poros o disrupciones en la superficie, comprometiendo la principal pared defensiva de la célula. Esta brecha permite que las moléculas antibióticas convencionales, que antes estaban bloqueadas, ingresen a la célula y ejecuten su función antibacteriana. Este enfoque sinérgico restauró la actividad antibiótica contra patógenos gramnegativos resistentes a los medicamentos, incluidos Escherichia coli y aislamientos clínicos de Acinetobacter baumannii, una de las principales causas de infecciones adquiridas en el hospital.
El estudio ofrece una innovadora estrategia basada en materiales contra la resistencia a los antimicrobianos. Alterando físicamente las membranas bacterianas, estas nanopartículas son menos susceptibles a la evolución de la resistencia. Actúan como adyuvantes potentes, revitalizando y prolongando la vida útil de muchos antibióticos existentes. El enfoque no solo aborda una grave crisis sanitaria mundial, sino que abre también la puerta a nuevas aplicaciones clínicas, como los recubrimientos antibacterianos, que proporcionan una herramienta versátil y de alto impacto para combatir las infecciones multirresistentes a fármacos en todo el mundo.
“Estas nanopartículas actúan como un aliado perfecto para los antibióticos”, afirma el Dr. Martijn Zwama, autor principal. “No matan las bacterias directamente, sino que facilitan el trabajo de los antibióticos. Esta sinergia superó la resistencia en algunas de las bacterias más resistentes. Este enfoque de ‘revivir’ los antibióticos ofrece una vía prometedora y sostenible para abordar la crisis de la RAM”.






